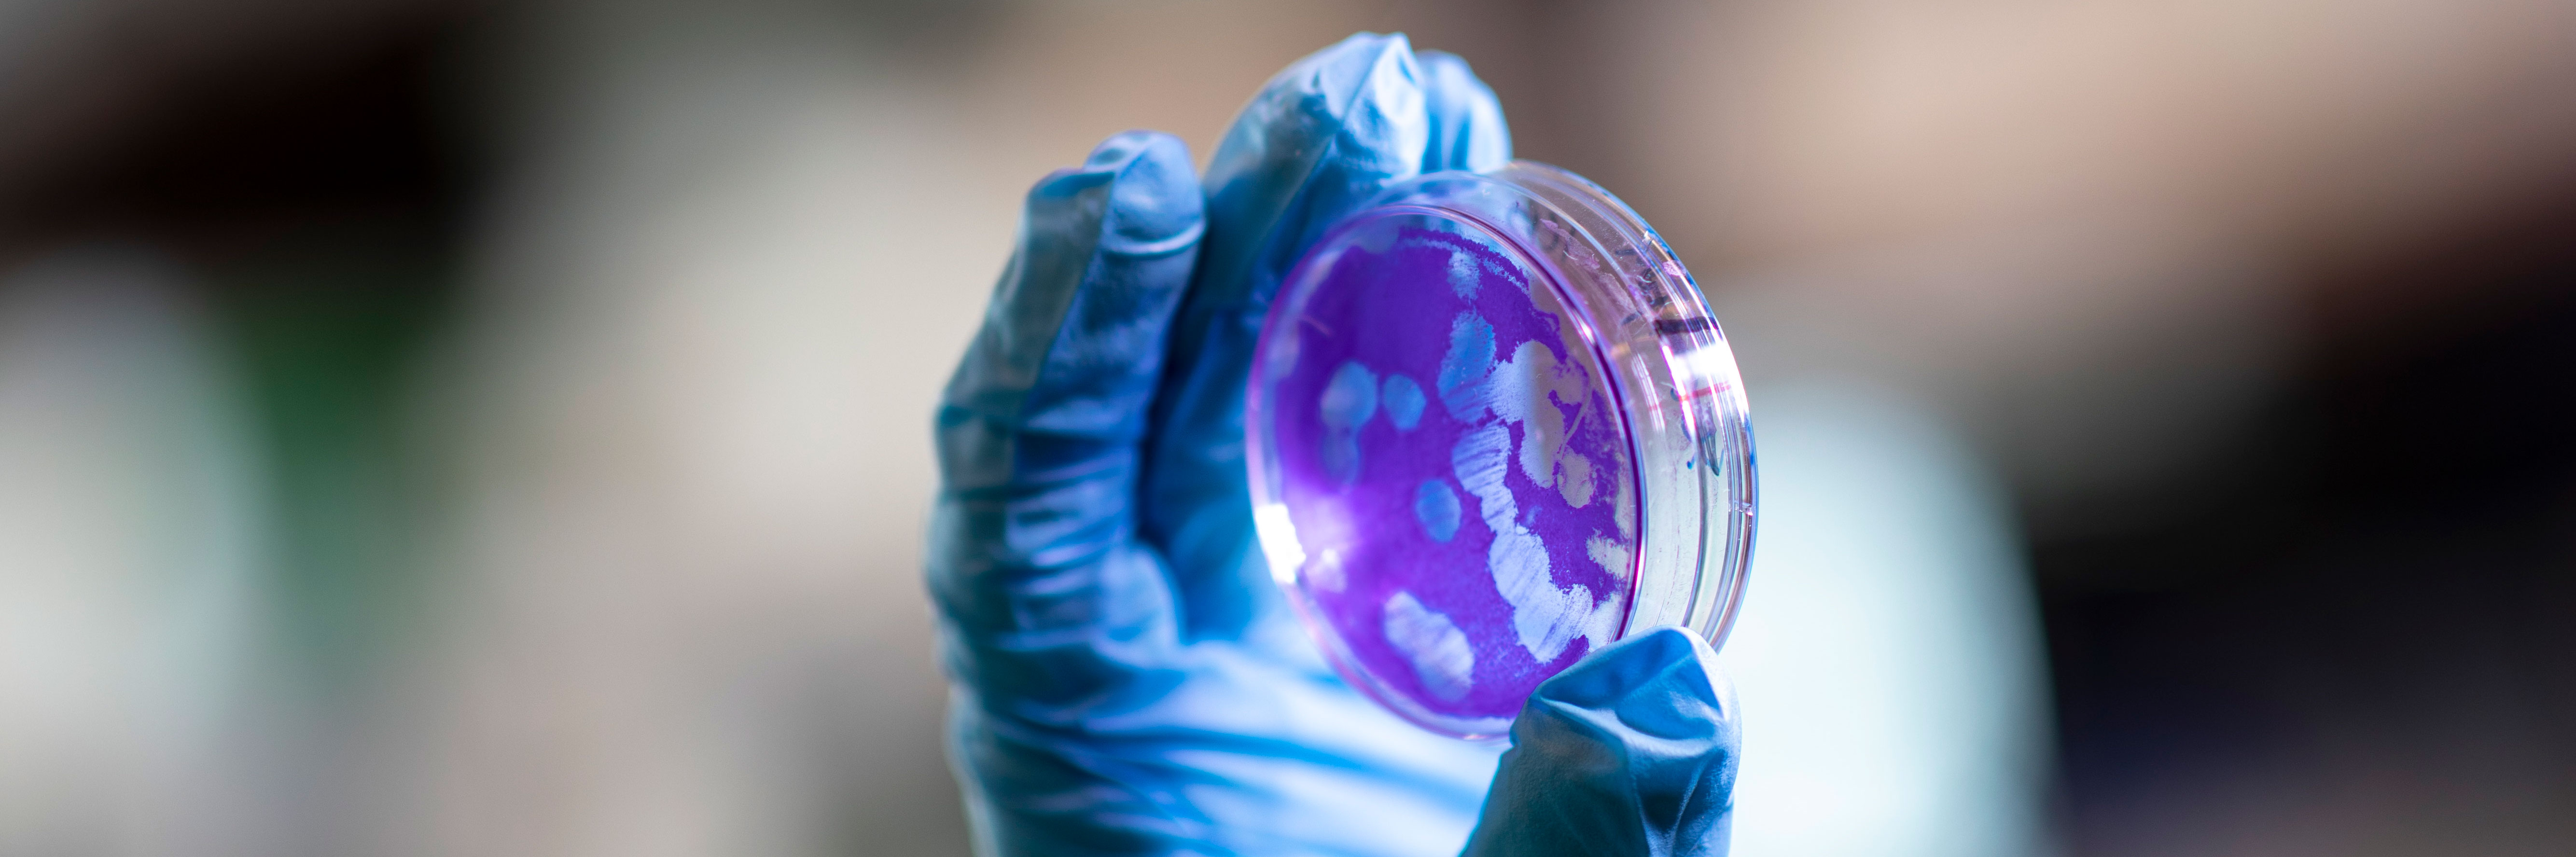

Responsible, Ethical & Secure Conduct of Research
At UAlbany, we are committed to upholding the highest standards of ethical conduct in all our research activities. Our research compliance framework ensures that all research is conducted with integrity, respect and responsibility. This framework is designed to protect the rights, dignity and welfare of research participants, promote transparency and accountability, and foster a culture of ethical research practices.
We believe that ethical research is fundamental to advancing knowledge and contributing to societal well-being. Our policies and procedures are aligned with national and international guidelines, and we continuously strive to improve our practices through ongoing education and training.
Under the Responsible Conduct of Research (RCR) umbrella, the Office of Regulatory and Research Compliance (ORRC) coordinates institution-wide research compliance policies and procedures, in partnership with researchers and institutional stakeholders, to ensure the University meets its obligations to regulators, accreditors, employees and students.
Contact ORRC at [email protected] or 518-437-3850. Visit our Staff Directory to reach individual staff members.
Report Research Misconduct
Anyone may use ORRC’s Anonymous Reporting Form to report any concerns regarding research conducted at UAlbany.
The Vice President for Research & Economic Development serves as UAlbany’s Research Integrity Officer (RIO), as outlined in the University’s Policy and Procedures on Misconduct in Research and Scholarship.
The Research Compliance Officer (RCO) is the Vice President’s designee and reports directly to the Vice President. The RCO works with various University committees, boards and offices to monitor specific areas of research compliance.
Contact UAlbany’s Research Compliance Officer at [email protected] or 866-857-5459. Please visit our Staff Directory to contact other members of the ORRC team.
Keep Up with Regulatory Changes
In recent months, the research landscape has experienced a notable surge in new regulations, guidance updates and compliance expectations across federal, state and institutional levels.
From evolving data privacy requirements to enhanced oversight on foreign collaborations and human subjects protections, the pace and complexity of regulatory change have accelerated significantly.
To help our research community stay informed and aligned, we’ve compiled a resource that outlines the most impactful new rules. This living document is designed to support researchers in navigating the shifting regulatory terrain with clarity and confidence.
Please reach out to the team at [email protected] or 518-437-3850 with any questions or concerns.
General Updates
- Requirement to disclose participation in Malign Foreign Talent Recruitment Programs
- Procedures for providing, transferring or allowing access to bulk sensitive personal data
- Public Health Service Policies on Research Misconduct
Agency-specific Updates
- National Science Foundation (NSF)
- National Institutes of Health (NIH)
- NIH's Implementation of Common Forms for Biographical Sketch and Current and Pending (Other) Support for Due Dates on or after January 25, 2026 (NOT-OD-26-018)
- Research Security Training Requirements for NIH (NOT-OD-26-017)
- Security best practices for controlled-access genomic data
- Public Access Policy (Access FAQs on the Public Access Policy.)
Review Monthly Hot Topics
Each month, the Office of Regulatory and Research Compliance (ORRC) sends our email newsletter, Hot Topics, to all UAlbany faculty and staff members.
Each issue provides an overview of a research compliance topic. Please review our Research Protections, Research Security and Research Training web content for detailed guidance.
| Date | Topic | Area |
|---|---|---|
| October 2025 | The use of Social Media (SM) data in Research | Institutional Review Board (IRB) |
| September 2025 | Annual Certification of Disclosures of Outside Interests | Disclosures |
| August 2025 | IACUC Information and Updates | Institutional Animal Care and Use Committee (IACUC) |
| July 2025 | Research Training Requirements | Office of Regulatory and Research Compliance (ORRC) |
| June 2025 | IRB Online Survey Tips | Institutional Review Board (IRB) |
| May 2025 | Research Security Reviews | Research Security |
| April 2025 | IRB Data Definitions and Examples | Institutional Review Board (IRB) |
| March 2025 | Research Security Initiatives | Research Security |
| January 2025 | Safeguarding Research | Office of Regulatory and Research Compliance (ORRC) |
| November 2024 | Understanding Research Agreement Reviews | Data Use Agreements (DUA) |
| October 2024 | Grant Congruency Reviews | Research Security |
| September 2024 | Annual Certification of Disclosures | Disclosures |
| August 2024 | Planning Research in Kindergarten through Twelfth Grade Settings | Institutional Review Board (IRB) |
| July 2024 | Responsible and Ethical Conduct of Research | Research Protections |
| June 2024 | Managing Research Data | Research Security |
| May 2024 | What Outside Interests Need Disclosing | Disclosures |
| April 2024 | What's Needed in an Animal Use Protocol | Institutional Animal Care and Use Committee (IACUC) |
| February 2024 | Export Controls and International Travel | Exports Control |
| January 2024 | Consent in Research with Human Subjects | Institutional Review Board (IRB) |

Research Protections
Please click on a topic below to access detailed instructions and documents/forms.
Questions? Contact Assistant Director for Research Protections Kanako Sumida-Ervin at [email protected] or 518-437-3844.
Human Participants
The Institutional Review Board (IRB) reviews all UAlbany research and teaching involving human subjects.
Visit the Human Participants webpage to:
- Learn about how UAlbany reviews research with human subjects
- Determine if IRB approval is required
- Meet with IRB staff
- Obtain IRB review
- Arrange for an IRB Reliance Agreement
- Conduct research at UAlbany as an external investigator
- Report concerns
Looking for a specific form?
- Get Started with Human Subjects Research
- Conduct New Research with Human Subjects
- Faculty Advisor’s Statement
- Informed Consent Worksheet & Templates
- Human Subjects Research Protocols
- Research at or with International Sites Form
- Single IRB Review (IRB Reliance) Forms
- Use of Experimental Equipment with Subjects Form
- Use or Collection of Human Tissue or Biological Samples Form
- Waiver or Alteration of Informed Consent
- Conduct Ongoing Research with Human Subjects
Care & Use of Animals
The Institutional Animal Care and Use Committee (IACUC) and Laboratory Animal Resources (LAR) review all UAlbany research involving the use of live vertebrate animals in research, teaching and/or training.
Visit the Care & Use of Animals webpage to:
- Learn about how UAlbany reviews the use of animals in research, teaching and training
- Meet with IACUC staff
- Meet with LAR staff
- Obtain IACUC review
- Order animals
- Report animal welfare concerns
Looking for a specific form?
- New Animal Use
- Ongoing Animal Use
- Addition or Deletion of Study Personnel Form
- Animal Authorization Form
- Controlled Substance Usage Log Form
- Protocol Closure Form
- Purchase Requisition Form
- Request for Modification of Approved Research Form
- Request to Receive an Internal Transfer of Animals Form
- Rodent Surgical Record Form
- Training Documentation Form
- Triennial Review Request Form
- Additional Resources
Biological Research
The Institutional Biosafety Committee (IBC) and Biosafety Officer implement and maintain a Biosafety Program to ensure that researchers, their staff, students and the community are not harmed or negatively impacted by University activities.
Visit the Institutional Biosafety Committee (IBC) webpage to:
- Learn about how UAlbany reviews biosafety protocols
- Access the Biosafety Manual
- Contact the IBC
- Determine if IBC approval is required
- Obtain IBC review
- Understand Principal Investigator responsibilities
Looking for a specific form?
- IBC Protocol Evaluation Form
- Biohazardous Agent Reference Document (BARD) Templates
- NIH Review Categories for Recombinant or Synthetic Nucleic Acid Research Form
- PI Self-assessment for Category 1 and/or Category 2 Research Designation
For additional information, please visit the Office of Environmental Health & Safety's Laboratory Safety webpage, which includes information on biosafety and laser, chemical and radiation safety.

Research Security
Please click on a topic below to access detailed instructions and documents/forms.
Questions? Contact Director of Research Security Terrell D. Rabb at [email protected] or 518-949-1003.
Disclosures
Each year, investigators and senior/key personnel are required to disclosure their and their family members’ external financial interests and significant obligations to ensure research remains objective and ethical.
Visit the Disclosures webpage to:
- Understand University policies on conflicts of interest, including foreign talent recruitment programs
- Complete the annual disclosure process
Looking for a specific form?
Research Data Management
Effectively managing research data involves establishing and following a plan for the systemic organization, storage and retrieval of data to ensure accuracy, accessibility and security.
Visit the Research Data Management webpage to:
- Access data management resources
- Complete required training
- Request a Data Use Agreement (DUA) review
- Understand the genomic data sharing process
Looking for a specific form?
Export Controls
Export controls regulate the transfer of items and information outside the United States.
While most University and research activities do not require an export control license, there are times when a license or documentation of compliance with the regulations is required.
Visit the Export Controls webpage to:
- Understand which activities require export controls
- Request an export controls review
- Access export controls education resources (training and templates)
Looking for a specific form?
Risk Assessments & Review for Research Security
Working on a proposal involving other entities? Request a risk assessment and review of proposed engagement by contacting [email protected].
Our office’s Research Security team will work with you to gather information on the potential collaborator(s) and the scope of the proposed collaboration to identify potential risk and management methods.
Research Security Concerns
If you believe a research security violation may have occurred, please report your concerns using one of these methods:
- Use ORRC’s Anonymous Reporting Form.
- Contact ORRC at [email protected] or 518-437-3850.
- Contact Director of Research Security Terrell D. Rabb at [email protected] or 518-949-1003.
Research Training
To conduct research activities at UAlbany, researchers — including staff, students, postdocs and others — must complete required ethics and compliance training.
Visit the Regulatory & Research Compliance Training webpage to:
- Use the CITI Program to complete online training
- Determine what training is required for your research activities
Questions? Contact [email protected].


